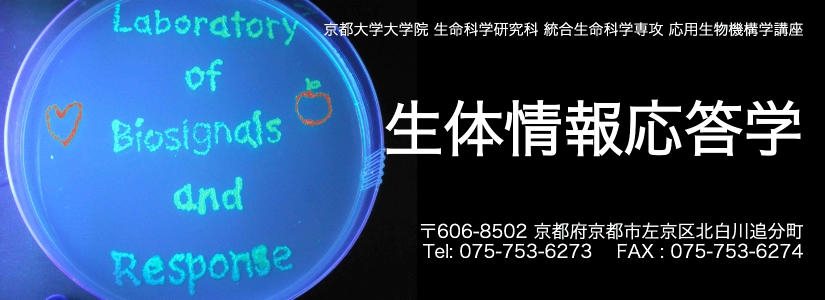

Publications
▼2026年
Kambe T.
“Nutrition and Physiology of Zinc”
Functional Food Factors,
Murakami A, Sakakibara H, Kawabata K and Miyoshi N (eds). Springer Nature, 257–264, 2026
Wagatsuma T, Yamamoto A, Nishimura Y, Kawami M, Ito J, Hirayama T, Masuda S,
Nakagawa K, Uchida Y, Kambe T.
“Zinc-MTF1-metallothionein axis plays critical roles in the defense against ferroptosis in human cells”
Free Radic Biol Med, 245, 390-404, 2026
神戸大朋
「必須ミネラルの世界」
理科教室, 69, 46-50, 2026
Kambe T, Yamamoto A, Nakakita K
“Elemental selectivity and homeostatic crosstalk among zinc, copper, and manganese in vertebrate cells”
Biosci Biotechnol Biochem, 90, 450-456, 2026
▼2025年
Yoshida M, Muraki N, Tajiri M, Hengphasatporn K, Sue K, Kubo T, Akashi S,
Shigeta Y, Kambe T, Furukawa Y
“Oxidative denaturation of Cu/Zn-superoxide dismutase associated with
neurodegenerative disease”
Protein Sci., 34, e70339, 2025
Kambe T, Miyazaki K, Shimoya M, Wagatsuma T
“Role of ZNT5-6 and ZNT7 in Zinc Enzyme Activation”
Zinc in Biology: Molecular Structures, Cellular Processes and Living Systems,
Yasui H and Kambe T (eds). Royal Society of Chemistry, 154-166, 2025
Hashimoto A, Nishito Y, Nakakita K, Kambe T
“Regulation of the Zn Absorption Process in the Small Intestine: Functional Insights
into Zn Transporters ZIP4 and ZNT1”
Zinc in Biology: Molecular Structures, Cellular Processes and Living Systems,
Yasui H and Kambe T (eds). Royal Society of Chemistry,79-95, 2025
▼2024年
Yuasa H, Miyazaki K, Kido T, Nishino K, Shiotsu M, Fukuwatari T, Suka M,
Nagao M, Kambe T
"Rate of hydrolysis of the phosphate esters of B vitamins is reduced by zinc
deficiency: In vitro and in vivo"
FASEB J., 38, e70025, 2024
Nishito Y, Fujishiro H, Nagamatsu S, Kambe T
"Reduced Mn uptake of pleiotropic ZIP8 SNP is caused by its loss of Mn-responsive
accumulation on the cell-surface"
Biosci Biotechol Biochem, 88, 1019-1026, 2024
Cheng R, Nishikawa Y, Wagatsuma T, Kambe T, Tanaka YK, Ogra Y, Tamura T,
Hamachi I
"Protein-Labeling Reagents Selectively Activated by Copper(I)"
ACS Chem Biol, 19, 1222-1228, 2024
Yuasa H, Morino N, Wagatsuma T, Munekane M, Ueda S, Matsunaga M, Uchida Y,
Katayama T, Katoh T, Kambe T
"ZNT5-6 and ZNT7 have an integral role in protein N-glycosylation through supplying
Zn2+ to Golgi α-mannosidase II"
J. Biol. Chem, 300, 107378, 2024
Nishito Y, Kamimura Y, Nagamatsu S, Yamamoto N, Yasui H, Kambe T
"Zinc and manganese homeostasis closely interact in mammalian cells"
FASEB J. 38, e23605, 2024
Sakata KI, Hashimoto A, Kambe T, Sato J, Ohga N, Yamazaki Y, Koyachi M,
Tatsuki I, Okada M, Taro O, Hikasa H, Kitagawa Y
"Expression analysis of zinc-metabolizing enzymes in the saliva as a new method of
evaluating zinc content in the body: two case reports and a review of the literature"
J Med Case Rep. 18, 198, 2024
神戸大朋
「分泌経路における銅酵素と亜鉛酵素の活性化機構」
生体の科学 特集 (生命現象を駆動する生体内金属動態の理解と展開) 75, 143-147, 2024
Okumura Y, Abe K, Sakai S, Kamei Y, Mori Y, Adachi Y, Takikawa M, Kitamura A,
Ohminami H, Ohnishi K, Masuda M, Kambe T, Yamamoto H, Taketani Y
"Elevated luminal inorganic phosphate suppresses intestinal Zn absorption in 5/6
nephrectomized rats"
Am J Physiol Renal Physiol. 326, F411-F419, 2024
Kakita N, Katayama K, Yasui T, Satake S, Aoi K, Jo H, Kim YK, Yamazaki M,
Hashimoto A, Kambe T
"Zinc transporter 1 expression in hepatocellular carcinoma correlates with prognosis: A
single-center retrospective study."
J Trace Elem Med Biol. 82,127354, 2024
▼2023年
Kambe T, Wagatsuma T
"Metalation and activation of Zn2+ enzymes via early secretory pathway-resident ZNT
proteins"
Biophysics Reviews, 4, 041302, 2023
神戸大朋
「メラニン生合成における亜鉛の重要性」
亜鉛栄養治療, 14, 16-23, 2023
神戸大朋
「亜鉛欠乏症のメカニズム:細胞外ATP代謝制御障害とアデノシンの減少」
脳神経内科, 99, 787-792, 2023
神戸大朋
「黒いメラニン色素生合成における亜鉛要求性の発見」(トピックス)
バイオサイエンスとインダストリー, 81, 518-519, 2023
神戸大朋
「メラニン色素生合成には亜鉛が必要である」(目で見るバイオ)
バイオサイエンスとインダストリー, 81, 488-489, 2023
Nishito Y, Hashimoto A, Kambe T
"Simple in vitro method to evaluate ZIP zinc transport ability through zinc transporter 1
and metallothionein expression measurements"
Methods Enzymol., 687: 207-239, 2023
神戸大朋
「亜鉛トランスポーターの解析から亜鉛の生理機能を探る」
日本栄養・食糧学会誌, 76, 207-216, 2023
Ikeda Y, Kawakami M, Yamada Y, Munekane M, Sano K, Mukai T, Kambe T,
Shitan N
"Chloroform Fraction of Panax Ginseng Extract Enhances Zip4-Mediated Zinc
Influx into the Cytosol"
BPB Reports, 6, 108-114, 2023
神戸大朋
「亜鉛による生体機能制御」
実験医学増刊 精密栄養学, 41, 144-149, 2023
Wagatsuma T, Suzuki E, Shiotsu M, Sogo A, Nishito Y, Ando H, Hashimoto H,
Petris MJ, Kinoshita M, Kambe T
"Pigmentation and TYRP1 expression are mediated by zinc through the early secretory
pathway-resident ZNT proteins"
Commun. Biol., 6, 403, 2023
Muto T, Kawase Y, Aiba K, Okuma M, Itsumura N, Luo S, Ogawa N, Tsuji T,
Kambe T
"Novel SLC30A2 mutations in the pathogenesis of transient neonatal zinc deficiency"
Pediatr. Investig., 7, 6-12, 2023
神戸大朋
「初期分泌経路でのタンパク質成熟化における亜鉛の重要性」
ファルマシア, 59, 212-216, 2023
▼2022年
Tanaka K, Taketani Y, Angeles-Agdeppa I, Kambe T
"Role of Vitamins and Minerals in Health and Diseases"
J. Nutr. Sci. Vitaminol., 68, S70-S72, 2022
Sim EZ, Enomoto T, Shiraki N, Furuta N, Kashio S, Kambe T, Tsuyama T,
Arakawa A, Ozawa H, Yokoyama M, Miura M, Kume S
"Methionine metabolism regulates pluripotent stem cell pluripotency and
differentiation through zinc mobilization"
Cell Rep. 40, 111120, 2022
Fujishiro H, Miyamoto S, Sumi D, Kambe T, Himeno S
"Effects of individual amino acid mutations of zinc transporter ZIP8 on manganese-
and cadmium-transporting activity"
Biochem. Biophys. Res. Commun. 616, 26-32, 2022
Wagatsuma T, Shimotsuma K, Sogo A, Sato R, Kubo N, Ueda S, Uchida Y,
Kinoshita M and Kambe T
"Zinc transport via ZNT5-ZNT6 and ZNT7 is critical for cell surface
glycosylphosphatidylinositol-anchored protein expression"
J. Biol. Chem. 298, 102011, 2022
Nagamatsu S, Nishito Y, Yuasa H, Yamamoto N, Komori T, Suzuki T, Yasui H
and Kambe T
"Sophisticated expression responses of ZNT1 and MT in response to changes in the
expression of ZIPs"
Sci. Rep. 12, 7334, 2022
Ueda S, Manabe Y, Kubo N, Morino N, Yuasa H, Shiotsu M, Tsuji T, Sugawara T
and Kambe T
"Early secretory pathway-resident Zn transporter proteins contribute to celluler
sphingolipid metabolism through activation of sphingomyelin phosphodiesterase 1"
Am J Physiol Cell Physiol, 322, C948-C959, 2022
神戸大朋
「亜鉛メタレーションによる細胞機能調節」
実験医学増刊 栄養・代謝物シグナルと食品機能, 40, 38-44, 2022
Hashimoto A and Kambe T
"Overview of the zinc absorption mechanism for improving zinc nutrition"
Metallomics Research, 2, MR202115, 2022
Ikeda Y, Munekane M, Yamada Y, Kawakami M, Amano I, Sano K, Mukai T,
Kambe T and Shitan N
"Enhancing effect of Panax ginseng on Zip4-mediated zinc influx into the cytosol"
J Ginseng Res. 46, 248-254, 2022
Kelleher SL, Alam S, Rivera OC, Barber-Zucker S, Zarivach R, Wagatsuma T,
Kambe T, Soybel DI, Wright J, Lamendella R
“Loss-of-function SLC30A2 mutants are associated with gut dysbiosis and alterations
in intestinal gene expression in preterm infants”
Gut Microbes, 14, 2014739, 2022
神戸大朋
健康維持に不可欠なミネラル・亜鉛の機能を探る
化学と生物, 60, 22-29, 2022
Fujishiro H and Kambe T
“Manganeze transport in mammals by zinc transporter family proteins, ZNT and ZIP”
J. Pharmacol. Sci. 148, 125-133, 2022
▼2021年
橋本彩子、神戸大朋
「消化管での亜鉛吸収機構に着目した亜鉛栄養の改善」
Trace Nutrients Research- 微量栄養素研究-, 38, 85-90, 2021
神戸大朋、辻徳治
「亜鉛の生体機能と細胞内輸送機構」
金属, 91, 38-44, 2021
神戸大朋
「ミネラルの働き」
食品免疫学事典、日本食品免疫学会(編)
朝倉書店 34-35, 2021
神戸大朋
「亜鉛欠乏症の病態」
日本医師会雑誌, 150, 464, 2021
森野菜穂、神戸大朋
「アルカリホスファターゼの活性化には亜鉛トランスポーターが重要な役割を果たす」
亜鉛栄養治療, 11, 13-21, 2021
Kambe T, Taylor KM, and Fu D
“Zinc transporters and their functional integration in mammalian cells”
J. Biol. Chem., 296, 100320, 2021
Tsuji T, Morita SY, Nakamura Y, IkedaY, Kambe T, Terada T
“Alterations in cellular and organellar phospholipid compositions of HepG2 cells during
cell growth”
Sci. Rep., 11, 2731, 2021
西藤有希奈、神戸大朋
「マンガン代謝維持機構における輸送体の役割 ―マンガン輸送体の輸送金属識別機構―」
生命金属ダイナミクス 生体内における金属の挙動と制御、監修:城 宜嗣、津本 浩平、編
集委員:古川良明、神戸 大朋
株式会社エヌ・ティー・エス, 58-65, 2021
神戸大朋
「生体内での亜鉛の機能とその代謝」
生命金属ダイナミクス 生体内における金属の挙動と制御、監修:城 宜嗣、津本 浩平、編
集委員:古川良明、神戸 大朋
株式会社エヌ・ティー・エス, 13-20, 2021
Yanagimichi M, Nishino K, Sakamoto A, Kurodai R, Kojima K, Eto N, Isoda H,
Ksouri R, Irie K, Kambe T, Masuda S, Akita T, Maejima K, Nagao M.
“Analyses of putative anti-cancer potential of three STAT3 signaling inhibitory
compounds derived from Salvia officinalis”
Biochem Biophys Rep. 25, 100882, 2021
Stocks CJ, von Pein JB, Curson JEB, Rae J, Phan MD, Foo D, Bokil NJ, Kambe T,
Peters KM, Parton RG, Schembri MA, Kapetanovic R, Sweet MJ
“LPS-inducible SLC30A1 drives human macrophage-mediated zinc toxicity against
intracellular Escherichia coli”
J Leukoc Biol, 109, 287-297, 2021
▼2020年
神戸大朋
亜鉛の基礎科学
Visual Dermatology, 19, 1010-1013, 2020
Suzuki E#, Ogawa N#, Takeda T#, Nishito Y#, Tanaka Y, Fujiwara T, Matsunaga M,
Ueda S, Kubo N, Tsuji T, Fukunaka A, Yamazaki T, Taylor KM, Ogra Y, and Kambe T
(#equally contribute)
“Detailed analyses of the crucial functions of Zn transporter proteins in alkaline
phosphatase activation”
J. Biol. Chem., 295, 5669-5684, 2020
Fukada T* and Kambe T* (*Corresponding author)
“Report for the Sixth Meeting of the International Society for Zinc Biology (ISZB-2019)”
Int J Mol Sci., 21, 611, 2020
神戸大朋
「亜鉛の体内での働き・亜鉛欠乏症の基礎的病態」
細胞 52, 113-115, 2020
神戸大朋
「微量元素の調節機構」
腎臓内科11, 107-114, 2020
Kambe T
“Metalation and maturation of zinc ectoenzymes: A perspective”
Biochemistry, 59, 74-79, 2020
Nishino K, Uesugi H, Hirasawa A, Ohtera A, Miyamae Y, Neffati M, Isoda H, Kambe
T, Masuda S, Irie K, Nagao M.
“Stimulation of insulin secretion by acetylenic fatty acids in insulinoma MIN6 cells
through FFAR1”
Biochem Biophys Res Commun., 522, 68-73, 2020
Kambe T and Takahashi M
“Biological functions of soyasaponins: The potential use to improve zinc nutrition”
Nuts and Seeds in Health and Disease, Second Edition
Preedy V.R. and Watson R.R. (eds): Elsevier, 93-102, 2020
Nishito Y, Luo S, and Kambe T
“Zinc transporters involved in vectorial zinc transport in intestinal epithelial cells”
Ion Channels and Transporters of Epithelia in Heatllh and Disease-2nd Edition
Hamilton K.L. and Devor D.C. (eds).
Springer, 447-465, 2020
▼2019年
Nishito Y, and Kambe T
“Zinc transporter 1 (ZNT1) expression on the cell surface is elaborately
controlled by cellular
zinc levels”
J. Biol. Chem., 294, 15686-15697, 2019
上田祥子、神戸大朋
「エクト型亜鉛要求性酵素の活性化機構:亜鉛栄養を絡めた考察」
Trace Nutrients Research-微量栄養素研究-, 36, 102-105, 2019
Kambe T, Suzuki E, Komori T
“Zinc transporters-A review and a new view from biochemistry”
Zinc Signaling-Second Edition
Fukada T. and Kambe T. (eds). Springer-Nature, 23-56, 2019
西藤有希奈、神戸大朋
「亜鉛輸送体の亜鉛状態に応答した発現および局在の制御機構」
亜鉛栄養治療, 10, 25-31, 2019
Katano H, Noba S, Taira S, Kambe T and Takahashi M
“A Solubility-Based Separation of Group B Soyasaponins from the Whole
Soybean Flour”
Anal. Sci., 35, 935-937, 2019
神戸大朋
「亜鉛トランスポーターを介したエクト型亜鉛要求性酵素の活性化」
食品・バイオにおける最新の酵素応用, シーエムシー出版, 231-238, 2019
西藤有希奈、橋本彩子、神戸大朋
「必須微量金属の消化管吸収の分子機構」
消化器・肝臓内科, 5, 475-482, 2019
Ogawa Y, Kinoshita M, Shimada S, Kambe T, and Kawamura T
“Zinc transporters in the epidermis”
J Dermatol, 46, e243-e245, 2019
武田貴成、笹川剛、駒井三千夫、神戸大朋
「細胞外アデニンヌクレオチド分解活性は亜鉛栄養状態を反映する」
栄養-Trends of Nutrition-, 4, 47-49, 2019
▼2018年
西藤有希奈、直木志保、神戸大朋
「生体内の亜鉛代謝制御における亜鉛輸送体の役割」
微量栄養素研究-, 35, 92-97, 2018
神戸大朋、長尾早枝子、福江和久、廣瀬潤子
「母乳中亜鉛の重要性を考える:亜鉛トランスポーターの変異と母乳中亜鉛量の調査報
告」
亜鉛栄養治療, 9, 28-35, 2018
武田貴成、神戸大朋
「亜鉛要求性酵素による細胞外ATP代謝の制御」
亜鉛栄養治療, 9, 22-27, 2018
神戸大朋
「日本人女性の遺伝子変異と乳児亜鉛欠乏症」
食と医療54-59, 2018
神戸大朋
「亜鉛栄養とヒトの健康」
アグリバイオ, 2, 1154-1158, 2018
Fukue K, Itsumura N, Tsuji N, Nishino K, Nagao M, Narita H and Kambe T
“Evaluation of the roles of the cytosolic N-terminus and His-rich loop of ZNT proteins
using ZNT2 and ZNT3 chimeric mutants”
Sci. Rep., 8, 14084, 2018
Ogawa Y, Kinoshita M, Mizumura N, Miyazaki S, Aoki R, Momosawa A, Shimada S,
Kambe T, Kawamura T.
“Purinergic Molecules in the Epidermis”
J Invest Dermatol, 138, 2486-2488, 2018
Takeda T, Miyazaki S, Kobayashi M, Nishino K, Goto T, Matsunaga M, Ooi M,
Shirakawa H, Tani F, Kawamura T, Komai M, and Kambe T
“Zinc deficiency causes delayed ATP clearance and adenosine generation in rats and
cell culture models”
Commun Biol, 1, 113, 2018
駒井三千夫、後藤知子、大日向耕作、神戸大朋、真柳祐希、白川 仁
消化管亜鉛シグナルによる食欲亢進作用のメカニズム
YAKUGAKU ZASSHI, 138, 1011-1016, 2018
武田貴成、神戸大朋
エクト型亜鉛酵素の亜鉛獲得による活性化機構
生化学, 90(3), 333-339, 2018
Okamura M, Yamanaka Y, Shigemoto M, Kitadani Y, Kobayashi Y, Kambe T, Nagao
M, Kobayashi I, Okumura K, and Masuda S
Depletion of mRNA export regulator DBP5/DDX19, GLE1 or IPPK that is a key enzyme
for the production of IP6, resulting in differentially altered cytoplasmic mRNA
expression and specific cell defect.
PLoS One. 13, e0197165, 2018
Fukada T* and Kambe T* (*Corresponding author)
“Editorial: Welcome to the World of Zinc Signaling”
Int J Mol Sci., 19, 785, 2018
Nishito Y and Kambe T
“Absorption mechanisms of iron, copper, and zinc: An overview”
J Nutr Sci Vitaminol., 64, 1-7, 2018
▼2017年
神戸大朋
「母乳栄養と亜鉛:亜鉛トランスポーターの変異により引き起こされる乳児亜鉛欠乏症」
生化学, 89, 881‒884, 2017
Kambe T, Matsunaga M and Takeda T
“Understanding the Contribution of Zinc Transporters in the Function of the Early Secretory Pathway”
Int J Mol Sci., 18, 2179, 2017
Kurata M, Morimoto M, Kawamura Y, Mursi IFA, Momma K, Takahashi M, Miyamae Y, Kambe T, Nagao M, Narita H, Shibuya Y, and Masuda S
“Inhibition of mRNA Maturation by Compounds Which Have a Flavonoid Skeleton”
Biochemistry and Molecular Biology, 2, 46-53, 2017
西藤有希奈、神戸大朋
「消化管での微量金属の吸収調節機構 -鉄、銅、亜鉛の吸収に関わる分子-」
消化と吸収, 39, 122−127, 2017
Golan Y, Kambe T* and Assaraf YG* (*Corresponding author)
“The role of the zinc transporter SLC30A2/ZnT2 in transient neonatal zinc deficiency”
Metallomics, 9, 1352-1366, 2017
Fujishiro H, Hamao S, Tanaka R, Kambe T and Himeno S
“Concentration-dependent roles of DMT1 and ZIP14 in cadmium absorption in Caco-2 cells”
J. Toxicol. Sci., 42, 559-567, 2017
Go S, Kurita H, Yokoo K, Inden M, Kambe T and Hozumi I
“Protective function of SLC30A10 induced via PERK-ATF4 pathway against 1-methyl-4-phenylpyridinium”
Biochem Biophys Res Commun., 490, 1307-1313, 2017
Hara T#, Takeda T#, Takagishi T, Fukue K, Kambe T* and Fukada T* (#equally contribute, *Corresponding author)
“Physiological roles of zinc transporters: molecular and genetic importance in zinc homeostasis”
J Physiol Sci, 67, 283–301, 2017
Tsuji T, Kurokawa Y, Chiche J, Pouyssegur J, Sato H, Fukuzawa H, Nagao M, and Kambe T
“Dissecting the process of activation of cancer-promoting zinc-requiring ectoenzymes by zinc metalation mediated by ZnT transporters”
J. Biol. Chem., 292, 2159–2173, 2017
Kurata M, Murata Y, Momma K, Fouad Ali Mursi I, Takahashi M, Miyamae Y, Kambe T, Nagao M, Narita H, Shibuya Y, Masuda S.
The isoflavone fraction from soybean presents mRNA maturation inhibition activity”
Biosci Biotechnol Biochem, 81, 551-554, 2017
▼2016年
橋本彩子、有本紗也加、神戸大朋
「消化管における亜鉛トランスポーターZIP4とZIP5の相互発現制御」
Trace Nutrients Research-微量栄養素研究-, 33, 122−127, 2016
小原隆史、小松なぎさ、逸村直也、神戸大朋、武藤雄一郎、西原卓宏、平井克樹、右田昌宏
「母体ZnT2遺伝子変異に基づく低亜鉛母乳による亜鉛欠乏性皮膚炎」
日本小児科学会雑誌, 120, 1649-1656, 2016
神戸大朋
「亜鉛トランスポーター研究から視た亜鉛バイオロジー」
JAACTニュースレター, 26, 4-15, 2016
Kambe T*, Fukada T*, Toyokuni S (*Corresponding author)
“Editorial: The coming of age of zinc biology”
Arch Biochem Biophys., 611, 1-2, 2016
辻徳治、神戸大朋
「分泌型亜鉛要求性酵素の亜鉛獲得・活性化メカニズム」
内分泌・糖尿病・代謝内科, 43, 115-120, 2016
Fujimoto S, Tsuji T, Fujiwara T, Takeda T, Merriman C, Fukunaka A, Nishito Y, Fu D, Hoch E, Sekler I, Fukue K, Miyamae Y, Masuda S, Nagao M, Kambe T
“The PP-motif in luminal loop 2 of ZnT transporters plays a pivotal role in TNAP activation”
Biochem. J., 473, 2611–2621, 2016
Miyamae Y, Nishito Y, Nakai N, Nagumo Y, Usui T, Masuda S, Kambe T, Nagao M
“Tetrandrine induces lipid accumulation through blockade of autophagy in a hepatic stellate cell line”
Biochem Biophys Res Commun, 477, 40-46, 2016
橋本彩子、神戸大朋
「亜鉛トランスポーターZIP4を標的とした亜鉛栄養の改善」
亜鉛栄養治療, 6, 67-72, 2016
神戸大朋
「亜鉛トランスポーターを標的にした亜鉛栄養改善」
日本臨牀,74, 1234-1238, 2016
Itsumura N, Kibihara Y, Fukue K, Miyata A, Fukushima K, Tamagawa-Mineoka R, Katoh N, Nishito Y, Ishida R, Narita H, Kodama H, Kambe T
“Novel mutations in SLC30A2 involved in the pathogenesis of transient neonatal zinc deficiency”
Pediatr Res., 80, 586-594, 2016
Nishito Y, Tsuji N, Fujishiro H, Takeda T, Yamazaki T, Teranishi F, Okazaki F, Matsunaga A, Tuschl K, Rao R, Kono S, Miyajima H, Narita H, Himeno S, Kambe T.
“Direct Comparison of Manganese Detoxification/Efflux Proteins and Molecular Characterization of ZnT10 Protein
as a Manganese Transporter”
J. Biol. Chem., 291, 14773-14787, 2016
Golan Y#, Itsumura N#, Glaser F, Berman B, Kambe T*, Assaraf YG*
(# equally contribute, * corresponding author)
“Molecular Basis of Transient Neonatal Zinc Deficiency: Novel ZnT2 Mutations Disrupting Zinc Binding and Permeation”
J. Biol. Chem., 291, 13546–13559, 2016
Kambe T, Nishito Y and Fukue K
“Zinc transporters in health and disease”
Molecular, Genetic, and Nutritional Aspects of Major and Trace Minerals
J.F. Collins (ed): Elsevier, 283-291, 2016
Kambe T, Takeda T, Nishito Y
“Activation of zinc-requiring ectoenzymes by ZnT transporters during the secretory process: Biochemical and molecular aspects”
Arch Biochem Biophys., 611, 37-42, 2016
Kimura T, Kambe T
“The Functions of Metallothionein and ZIP and ZnT Transporters: an Overview and Perspective”
Int J Mol Sci,, 17, 336, 2016
Yamada D, Saiki S, Furuya N, Ishikawa KI, Imamichi Y, Kambe T, Fujimura T, Ueno T, Koike M, Sumiyoshi K, Hattori N.
“Ethambutol neutralizes lysosomes and causes lysosomal zinc accumulation”
Biochem Biophys Res Commun., 471, 109-116, 2016
Hashimoto A, Nakagawa M, Tsujimura N, Miyazaki S, Kizu K, Goto T, Komatsu Y, Matsunaga A, Shirakawa H, Narita H, Kambe T* and Komai M
( * corresponding author)
“Properties of Zip4 accumulation during zinc deficiency and its usefulness to evaluate zinc status: A study of the effects of zinc deficiency during lactation”
Am J Physiol Regul Integr Comp Physiol., 310, R459-R468, 2016
Home
Projects
Members
Publications
Photos
Contact